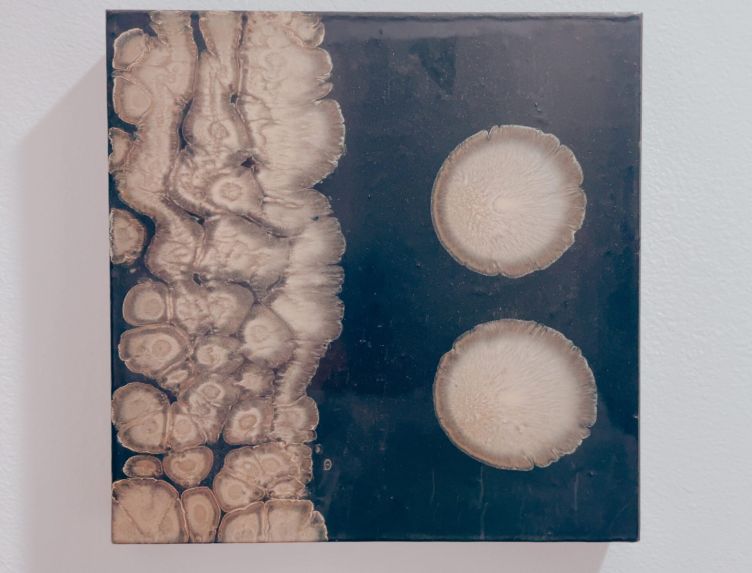

TRYST 2025: Ace Tiger’s First Foray into the Alternative Art Fair

The International Line-Up: Eight artists curated by Ace Tiger
Michael Adamson – Mathew Carter – Michelle Andrade – Noah Gould – Michelle Ohm – Adam Mars – John Weston – Michael Brunswick

AFTER-HOURS:
TRYST × ACE TIGER
Saturday, July 12, 2025
6:30 – 8:30 PM
What is TRYST
TRYST is an international art fair for artist-run-spaces and collectives as well as an international gathering to address the needs and future of global exchange for artist-run spaces, collectives and organizations, run through the Torrance Art Museum (TAM) and the City of Torrance. This will be the third edition of TRYST.
July 11–13, 2025
Fri 4-6 PM
Sat + Sun 12-6 PM
Fri 4-6 PM
Sat + Sun 12-6 PM

Del Amo Crossing
21535 Hawthorne Blvd, Torrance, CA
21535 Hawthorne Blvd, Torrance, CA
#12
Booth Space

Michael Brunswick ⚬ Michael Adamson ⚬ Mathew Carter ⚬ Michelle Andrade ⚬ Noah Gould ⚬ Michelle Ohm ⚬ Adam Mars ⚬ John Weston

Mrs. Danvers
by Michelle Ohm

A vivid collision of global voices curated by Ace Tiger

Zigzag
by Mathew Carter


Encore
by Adam Mars
two dots ( black and white )
by Michael Brunswick

AFTER-HOURS:
TRYST × ACE TIGER
TRYST × ACE TIGER
Saturday, July 12
6:30 – 8:30 PM
24411 Hawthorne Blvd
Torrance, CA 90505

Everything is Too Much
By Michelle Andrade

Getting to the Point
by John Weston
2025
July 11–13